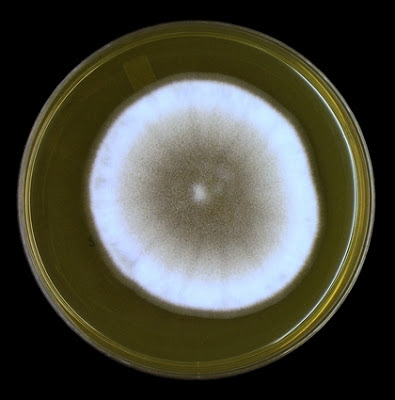

Aspergillus calidoustus - Fungus (Aspergillus ustus)
Note: A. calidoustus has previously been identified A.ustus.
A typical representative strain of Aspergillus ustus had been difficult to select as isolates exhibited a great deal deal of phenotypic variation, and more recently, demonstrable genotypic variation. As a result, recent taxonomic changes have shown there are currently eight separate species which comprise the Aspergillussection usti including the novel species A.calidoustus. Re-examination of clinical isolates previously identified as A.ustushas shown that a great number are actually attributed to A.calidoustus. As molecular analysis would be employed to speciate isolates with confidence, a procedure not routine to most clinical laboratories, I have included both names in this post.
Ecology: One source istates that Aspergillus ustus is among the most ubiquitous soil species, found more frequently in tropical and subtropical areas. For Aspergillus calidoustus in particular, another source states that it is present in low numbers in soilii.
Macroscopic Morphology:Aspergillus calidoustus exhibits rapid growth and will mature in about three days. Colonies may show variation in surface colour from a yellowish brown to a drab olive with possible greys. They may show a lighter coloured outer edge and droplets of purple exudate may appear on the surface of the maturing colony. The reverse is a yellowish brown colour. Texture was even and rather velvety.
Aspergillus calidoustus on SAB, ~5 days at 30o C.
Microscopic Morphology:Aspergillus calidoustus produces septate hyphae from which smooth-walled conidiophore stipes extend. Conidiophores may develop a brownish colour as they mature. Stipes are rather short (130 µm to 300 µm), though the ones measured on the isolate discussed here did not exceed about 150 µm in length. Vesicles, subspherical in shape, also were rather small (~7 µm to 15 µm dia.) From the vesicles, biseriate conidiogenous cells extend with the metulae being slightly shorter than the phialides. These conidiogenous cells cover the upper half to three quarters of the vesicle and produce round conidia (3.0 µm to 4.5 µm dia.) bearing a noticeably rough wall. A distinguishing feature is the irregular shaped and elongated Hülle cells this fungus is capable of producing, however, the production of Hülle cells may be photosensitive and some searching may be required.Note: All photos which follow were taken from a slide culture of the fungus using the DMD-108 Microscope/camera.
Aspergillus calidoustus (LPCB X250)
Hyphae with stipes bearing fruiting structures
Aspergillus calidoustus (LPCB X400)
Two Stipes (Conidiophores) bearing fruiting body
Aspergillus calidoustus - a closer look (X400+10, LPCB)
At this magnification the vesicle, conidiogenous cells & conidia are becoming more distinct.
Aspergillus calidoustus - yet closer (X1000+10, LPCB)
Ditto
Aspergillus calidoustus - Biseriate structue of the conidiogenous cells (metulae & phialides) are visible. (X1000+10, LPCB)
Aspergillus calidoustus - more of the same. The rough surface of the conidia is evident in this and some of the previous photos.
(X1000+10, LPCB)
Aspergillus calidoustus - one more photo showing the rather small vesicle, the biseriate conidiogenous cells and rough conidia.
(X1000+10, LPCB)
Aspergillus calidoustus - stepping back a bit, here we see the full length of the stipe (conidiophore) and can judge the size in comparison to the 100 micron bar at the upper right of the photo. A 'foot cell' appears at the base with the fruiting structure at the apex. (X250, LPCB)
Aspergillus calidoustus has rather short stipes. Published sources state that the length varies between 130 µm to 300 µm. My measurements in the above photo were somewhat shorter, between 70 µm and 120 µm in this field. (X400, LPCB)
Aspergillus calidoustus - at the apex of the conidiophore there is a rather small vesicle (~6.7 µm here) from which extend the metulae and phialide structures which comprise the biseriate conidiogenous cells that produce the conidia.
(X400+10, LPCB)
Aspergillus calidoustus - Biseriate structure bearing rough walled conidia are seen in this photo. Note the rather small vesicle from which the conidiogenous cells extend. (X1000+10, LPCB)
Aspergillus calidoustus - yet another view (X1000+10, LPCB)
Pathogenicity:Aspergillus calidoustus, though not highly pathogenic, is opportunistic and emerging as an infectious agent particularly in immunocompromised patients. A.calidoustus is capable of colonizing water distribution systems and has been isolated from heated water installations. This may be of concern in health care facilities where colonized water systems may be a source of infection for susceptible patients. Sites of infection range from pulmonary, heart, cutaneous (particularly burns) to isolation from otitis media. A.calidoustus may exhibit increased resistance to some antifungal drugs however that discussion is beyond the scope of this post.
* * *
ii Medically Important Fungi (5th ed.) -A Guide To Identification: Davise H. Larone, ASM Press, 2011
* * *